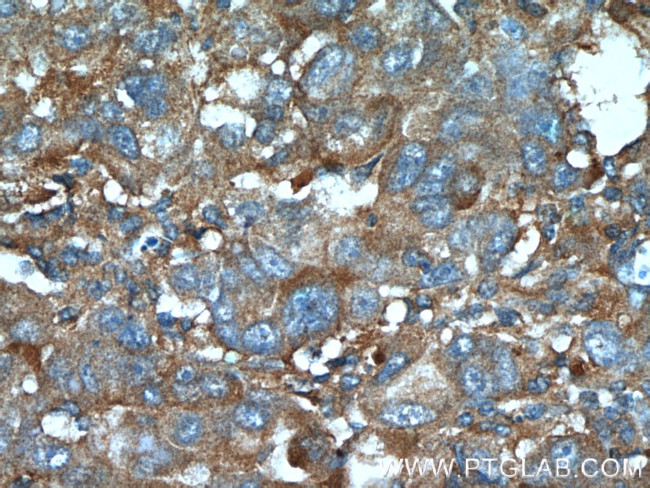
IGFBP7 Antibody in Immunohistochemistry (Paraffin) (IHC (P))
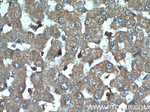
IGFBP7 Antibody in Immunohistochemistry (Paraffin) (IHC (P))

Search
Proteintech
IGFBP7 Polyclonal Antibody
{{$productOrderCtrl.translations['antibody.pdp.commerceCard.promotion.promotions']}}
{{$productOrderCtrl.translations['antibody.pdp.commerceCard.promotion.viewpromo']}}
{{$productOrderCtrl.translations['antibody.pdp.commerceCard.promotion.promocode']}}: {{promo.promoCode}} {{promo.promoTitle}} {{promo.promoDescription}}. {{$productOrderCtrl.translations['antibody.pdp.commerceCard.promotion.learnmore']}}
产品信息
19961-1-AP
种属反应
宿主/亚型
分类
类型
抗原
偶联物
形式
浓度
规格
纯化类型
保存液
内含物
保存条件
运输条件
靶标信息
This gene encodes a member of the insulin-like growth factor (IGF)-binding protein (IGFBP) family. IGFBPs bind IGFs with high affinity, and regulate IGF availability in body fluids and tissues and modulate IGF binding to its receptors. This protein binds IGF-I and IGF-II with relatively low affinity, and belongs to a subfamily of low-affinity IGFBPs. It also stimulates prostacyclin production and cell adhesion. Alternatively spliced transcript variants encoding different isoforms have been described for this gene, and one variant has been associated with retinal arterial macroaneurysm.
仅用于科研。不用于诊断过程。未经明确授权不得转售。
生物信息学
蛋白别名: angiomodulin; IBP-7; IBP7; IGF-binding protein 7; IGFBP; IGFBP rP1; IGFBP-7; IGFBP-rP1; Insulin like growth factor binding protein; Insulin-like growth factor-binding protein 7; MAC25; MAC25 protein; PGI2-stimulating factor; Prostacyclin-stimulating factor; TAF; Tumor-derived adhesion factor; unnamed protein product
基因别名: AGM; FSTL2; IBP-7; IGFBP-7; IGFBP-7v; IGFBP7; IGFBPRP1; MAC25; PSF; RAMSVPS; TAF
UniProt ID: (Human) Q16270, (Mouse) Q61581
Entrez Gene ID: (Human) 3490, (Mouse) 29817, (Rat) 289560